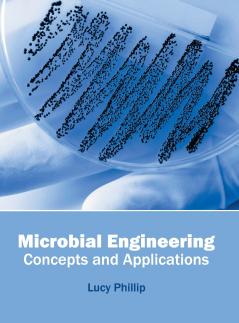
Microbial Engineering

English
Hardback
₹13781
(All inclusive*)
Delivery Options
Please enter pincode to check delivery time.
*COD & Shipping Charges may apply on certain items.
Review final details at checkout.
Looking to place a bulk order? SUBMIT DETAILS
Delivery Options
Please enter pincode to check delivery time.
*COD & Shipping Charges may apply on certain items.
Review final details at checkout.
About The Book
Description
Author
Microbial engineering is an important branch of applied biological sciences and finds applications across a wide range of disciplines such as agriculture pharmaceutics etc. This book contains some path-breaking studies in the field of microbial engineering. Researches revolving around biocatalysis biotransformation biosynthesis etc. have been presented in this book. This book focuses on the applications of microbial engineering for industrial purposes. Students researchers experts and all associated with microbial engineering and allied fields will benefit alike from it.
Details
ISBN 13
9781682861349
Publication Date
-30-05-2016
Pages
-220
Weight
-682 grams
Dimensions
-216x280x14.29 mm